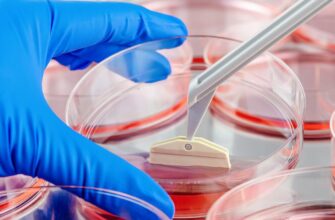

Новости науки
Новости науки
Новое исследование колумбийских ученых указывает на
Новости науки
Согласно исследованию, проведенному испанскими учеными
Новости науки
Группа ученых обнаружила в организме молекулярный механизм
Новости науки
Китайские ученые активно работают над созданием нового
Археологи обнаружили уникальную находку на юго-западе
Новое исследование, опубликованное в научном журнале
Новое научное исследование ставит под сомнение широко
Новости науки
Согласно исследованию, проведенному испанскими учеными
Японские исследователи обнаружили новаторский способ
Исследователи из Уханьского университета (Китай) обнаружили